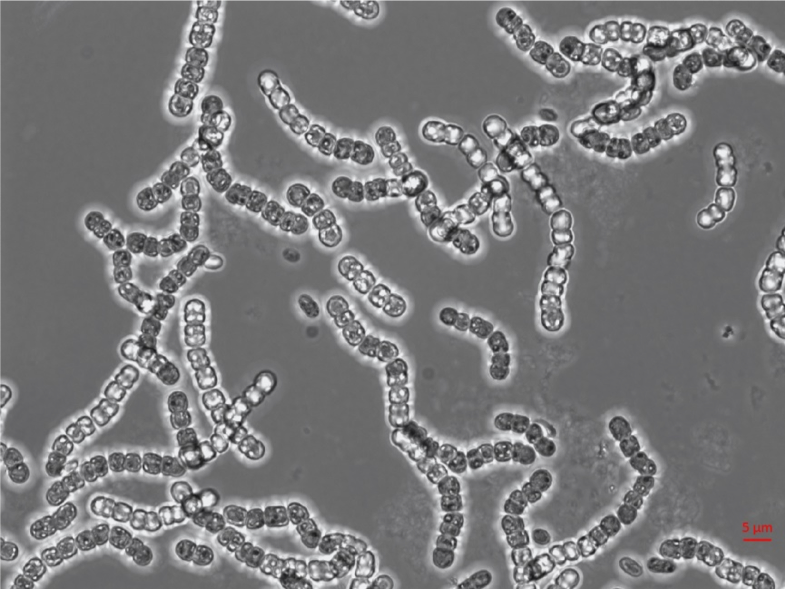
Katrin Hammerschmidt tweet media

Katrin Hammerschmidt
234 posts


@Hammerschmidt_K
#Evolution #Multicellularity #DivisionOfLabour #MajorTransitions #Individuality #LifeCycles #Symbiosis #PhilosophyOfBiology

It was quite a journey, but a lot of fun. Thanks to @Project_Telos for making this interdisciplinary project possible. For more context see: osf.io/preprints/osf/…


I'm thrilled to announce the publication of our new paper in *Nature Communications*. This work is the result of a collaborative effort between theoretical (@geeklhem)and experimental biologists (@Hammerschmidt_K), as well as philosophers. rdcu.be/dPP0I













We are excited to share our new @NaturePlants article, "Theoretical assessment of persistence and adaptation in weeds with complex life cycles"! :link: nature.com/articles/s4147… @GokhaleCS @MPI_EvolBio :thread:







Always wanted to understand how multicellularity and task division came about ? Daniel Rozen has an exciting PhD opportunity on experimental evolution of microbial multicellularity @LeidenBiology @LeidenScienceEN universiteitleiden.nl/en/vacancies/2…






Welche Rolle spielt Empathie für #Lehrkräfte? Wie können angehende Lehrkräfte im #Studium unterstützt werden? Und was beeinflusst die #Lernmotivation von SuS? Das sind nur einige Themen des neuen IPN Journals. Jetzt kostenlos herunterladen unter 👇ipn.uni-kiel.de/de/publikation… #twlz